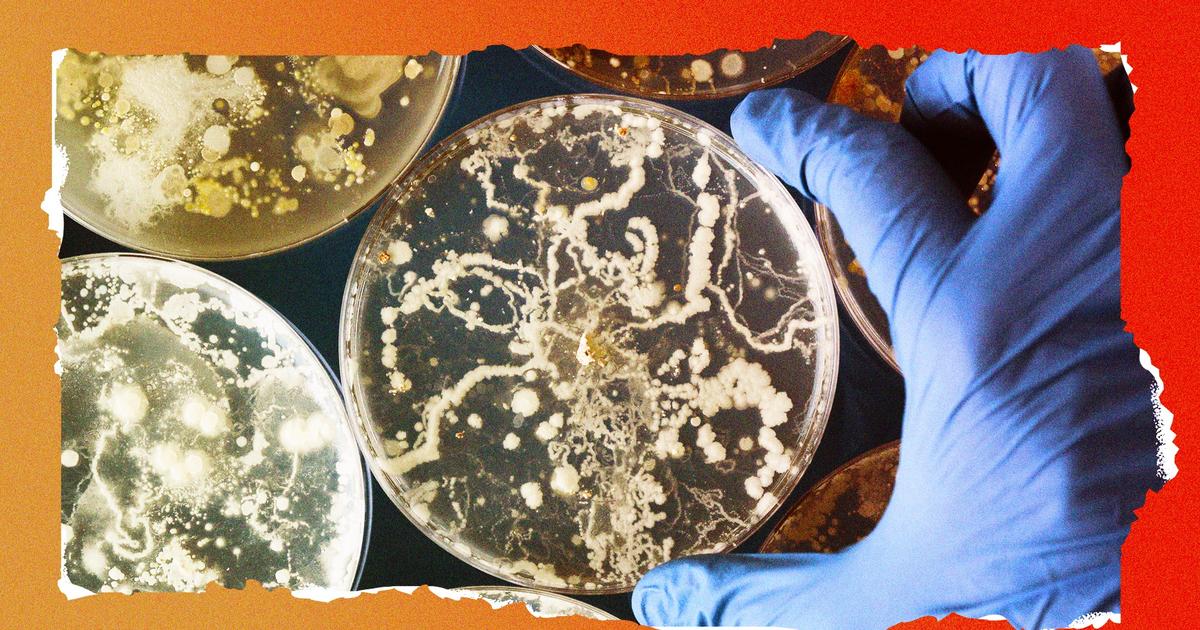

Menu
Rechercher
“Ils se sont embrassés sur le yacht” : Katy Perry et Justin Trudeau, la rumeur de...
Depuis plusieurs mois, des rumeurs d’une relation entre Katy Perry et Justin Trudeau se propagent sur la toile. Une idylle qui semble se confirmer.
Alors que les descentes s'intensifient, l'économie latino de Chicago s'effondre
Les commerces des quartiers à forte population immigrée de cette ville du Midwest sont en péril, alors que les descentes de police menées par l'administration du président américain Donald Trump se propagent dans les communautés, incitant les...
Des cybercriminels propagent des applications frauduleuses via Google : attention aux logiciels...
Des pirates informatiques profitent des résultats de recherche Google pour diffuser de fausses applications contenant des logiciels malveillants. Cette méthode trompeuse vise à infecter les appareils des internautes peu vigilants lors du téléchargement d’applications en ligne.
Meurtre de Charlie Kirk: Manuel Bompard (LFI) accuse "l'extrême droite d'inverser les...
Manuel Bompard, le coordinateur de La France Insoumise était l'invité de Guillaume Daret dans BFM Politique ce dimanche 14 septembre. Il est notamment revenu sur le meurtre de Charlie Kirk aux États-Unis.
Asthme : comment expliquer le pic de la rentrée ? - 14/09
Selon Santé publique France, le nombre de passages aux urgences pour crise d'asthme chez les moins de quinze ans est en hausse cette année. La principale cause serait le retour à la vie en collectivité, où les infections virales respiratoires se propagent plus facilement. Comment...
Quand des bactéries artificielles coloniseront la planète sans que rien ne les arrête
LES INCROYABLES SCÉNARIOS DE LA FIN DU MONDE (2/6) - Créées comme l’image inversée des pathogènes naturels, les bactéries miroir pourraient résister à tous leurs prédateurs. Si elles se propagent, leur impact sur les écosystèmes pourrait être...
Un important incendie en cours dans l'Aude, des moyens terrestres et aériens déployés
L'incendie s'est déclaré ce mardi 5 août dans le secteur de la commune de Ribaute. Selon la préfecture de l'Aude, les flammes se propagent vers le village de Saint-Laurent-de-la-Cabrerisse.
Un incendie consume cinq hectares de forêt au sud de la Charente-Maritime, une cinquantaine de...
Cinq hectares de forêt ont brulé ce samedi après-midi, à Clérac, au sud de la Charente-Maritime. Une cinquantaine de pompiers et l'hélicoptère de la Sécurité civile ont été dépêchés sur place pour éviter que les flammes ne se propagent.
Qu’est-ce qu’un tsunami ?
Un tsunami provoque des ondes en surface de l'océan, qui se propagent rapidement. Leur vitesse diminue en abordant les côtes, mais la hauteur des vagues augmente. Les tsunamis peuvent être provoqués par des éruptions volcaniques sous-marines, ou des séismes, comme le...
Canicule : la voiture d'un couple de personnes âgées prend feu en pleine route, ils...
Sous une chaleur accablante, un couple de personnes âgées a vu sa voiture s'embraser sur une départementale de la Creuse. Ils ont pu s'extraire du véhicule avant que les flammes ne le détruisent et ne se propagent à la végétation déjà sèche.
 lykhubs
lykhubs